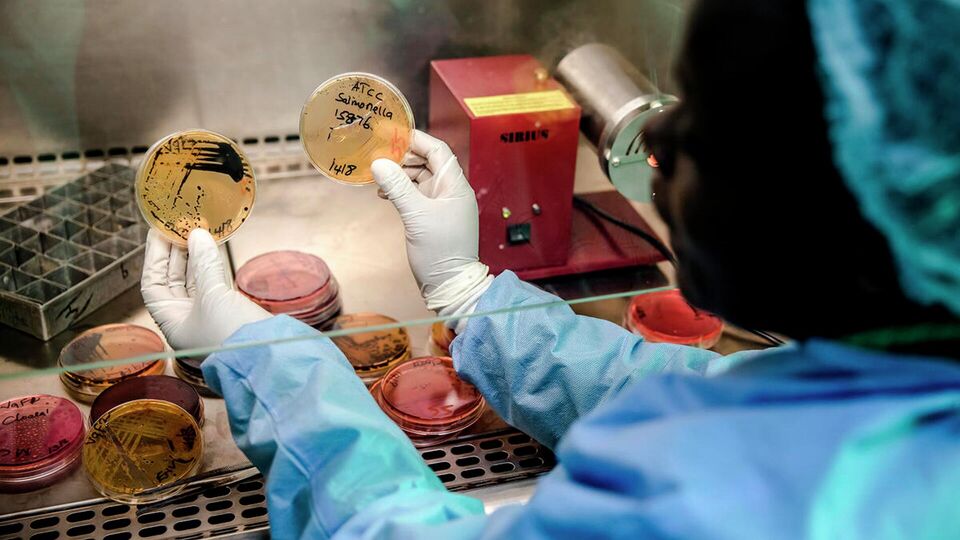

Круглый стол в рамках Всемирной недели повышения осведомленности о проблеме устойчивости к противомикробным препаратам — 2025.
Участники:
- директор Отделения Продовольственной и сельскохозяйственной организации Объединенных Наций (ФАО) для связи с Российской Федерацией Олег КОБЯКОВ;
- представитель Программы ООН по окружающей среде (ЮНЕП) в Российской Федерации Владимир МОШКАЛО;
- специалист по общественному здравоохранению Всемирной организации здравоохранения (ВОЗ) в Российской Федерации Татьяна КОЛПАКОВА;
- руководитель Российского референс-центра ФАО по устойчивости к противомикробным препаратам в пищевой продукции и сельском хозяйстве (ЦНИИЭ Роспотребнадзора) Игорь МАНЗЕНЮК;
- руководитель Референс-центра по остаточному количеству антибиотиков в продовольственном сырье и пищевых продуктах и антибиотикорезистентности бактерий Роспотребнадзора Нина КУЛИКОВА.
К участию приглашены: представители руководства Федеральной службы по ветеринарному и фитосанитарному надзору, Федеральной службы по надзору в сфере защиты прав потребителей и благополучия человека, Министерства здравоохранения, представители Регионального представительства ВОЗЖ по Европе и Европейского регионального бюро Всемирной организации здравоохранения.
С 18 по 24 ноября пройдет Всемирная неделя повышения осведомленности о проблеме устойчивости к противомикробным препаратам. В 2025 году ее девиз — "Время действовать: защитим настоящее, проявим заботу о будущем!".
Организаторами круглого стола являются представительства Продовольственной и сельскохозяйственной организации Объединенных Наций (ФАО), Всемирной организации здоровья животных (ВОЗЖ), Всемирной организации здравоохранения (ВОЗ) и программы ООН по окружающей среде (ЮНЕП) в Российской Федерации.
Вход для представителей СМИ только при наличии предварительной аккредитации при предъявлении паспорта и действительного редакционного удостоверения, подтверждающего принадлежность журналиста к СМИ, от которого он аккредитован.
ММПЦ "Россия сегодня" оставляет за собой право отказа в аккредитации без объяснения причин.
Участники:
- директор Отделения Продовольственной и сельскохозяйственной организации Объединенных Наций (ФАО) для связи с Российской Федерацией Олег КОБЯКОВ;
- представитель Программы ООН по окружающей среде (ЮНЕП) в Российской Федерации Владимир МОШКАЛО;
- специалист по общественному здравоохранению Всемирной организации здравоохранения (ВОЗ) в Российской Федерации Татьяна КОЛПАКОВА;
- руководитель Российского референс-центра ФАО по устойчивости к противомикробным препаратам в пищевой продукции и сельском хозяйстве (ЦНИИЭ Роспотребнадзора) Игорь МАНЗЕНЮК;
- руководитель Референс-центра по остаточному количеству антибиотиков в продовольственном сырье и пищевых продуктах и антибиотикорезистентности бактерий Роспотребнадзора Нина КУЛИКОВА.
К участию приглашены: представители руководства Федеральной службы по ветеринарному и фитосанитарному надзору, Федеральной службы по надзору в сфере защиты прав потребителей и благополучия человека, Министерства здравоохранения, представители Регионального представительства ВОЗЖ по Европе и Европейского регионального бюро Всемирной организации здравоохранения.
С 18 по 24 ноября пройдет Всемирная неделя повышения осведомленности о проблеме устойчивости к противомикробным препаратам. В 2025 году ее девиз — "Время действовать: защитим настоящее, проявим заботу о будущем!".
Организаторами круглого стола являются представительства Продовольственной и сельскохозяйственной организации Объединенных Наций (ФАО), Всемирной организации здоровья животных (ВОЗЖ), Всемирной организации здравоохранения (ВОЗ) и программы ООН по окружающей среде (ЮНЕП) в Российской Федерации.
Вход для представителей СМИ только при наличии предварительной аккредитации при предъявлении паспорта и действительного редакционного удостоверения, подтверждающего принадлежность журналиста к СМИ, от которого он аккредитован.
ММПЦ "Россия сегодня" оставляет за собой право отказа в аккредитации без объяснения причин.